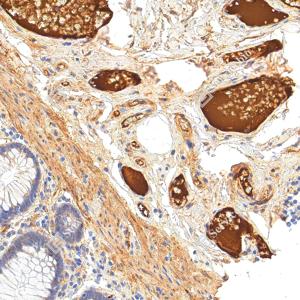
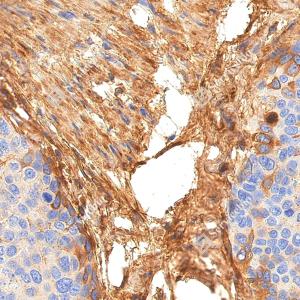
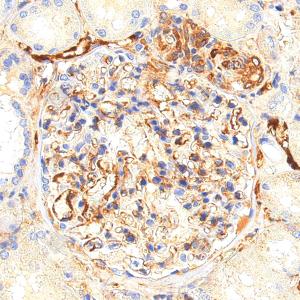

Recombinant Anti-Fibronectin antibody (Rabbit mAb)
- 50 μL
产品信息
|
蛋白质全称 |
纤连蛋白 |
|
别名 |
FN, Fn1, CIG, Cold-insoluble globulin, FINC, GFND2, LETS, MSF, Migration stimulating factor, ED-B, FNZ, GFND, LETS, MSF, fibronectin 1, Cold insoluble globulin, ED B, Fibronectin, FN1, FNZ |
|
Uniprot ID |
P02751 |
|
免疫原 |
人Fibronectin重组蛋白 |
|
抗体亚型 |
IgG, κ |
|
克隆号 |
SB271 |
|
预测分子量./观测分子量. |
272 kDa / 300 kDa |
|
纯化方式 |
亲和纯化 |
|
亚细胞定位 |
分泌型, 胞外空间, 胞外基质 |
应用
| 应用 | 物种 | 稀释 | 阳性样品 |
| WB 免疫印迹 | 人, 小鼠, 大鼠 | 1: 500-1: 1000 | 血浆, 血清, Huh7细胞 |
| IHC/IF 免疫组织化学/免疫荧光 | 人, 小鼠, 大鼠 | 1: 1500-1: 3000 | 肾, 肺, 结肠 |
背景
Fibronectins bind cell surfaces and various compounds including collagen, fibrin, heparin, DNA, and actin. Fibronectins are involved in cell adhesion, cell motility, opsonization, wound healing, and maintenance of cell shape. Involved in osteoblast compaction through the fibronectin fibrillogenesis cell-mediated matrix assembly process, essential for osteoblast mineralization. Participates in the regulation of type I collagen deposition by osteoblasts.
图像
|
|
WB检测Fibronectin蛋白(货号 YB152104). 样品: 经RIPA裂解液(货号Y2013)处理的蛋白质. 封闭: 3%脱脂牛奶(货号YC310012)溶于TBST溶液, 室温孵育1小时. —抗: 1: 500稀释, 4℃ 孵育过夜. 二抗: HRP标记山羊抗兔IgG (H+L) (货号YB23314), 1: 5000稀释, 室温孵育1小时. |
|
|
IHC检测Fibronectin蛋白(货号 YB152104). 样品: 人结肠, 4%多聚甲醛 (货号Y1112) 固定12-24小时. 抗原修复: 柠檬酸抗原修复液(干粉, pH 6.0) (Y1212), 高压锅均匀喷气计时2分钟. —抗: 1: 3000稀释, 4℃ 孵育过夜. 二抗: S-vision免疫组化多聚二抗(山羊抗兔),即用型 (货号Y1313), 室温孵育20分钟. |
|
|
IHC检测Fibronectin蛋白(货号 YB152104). 样品: 人食管癌, 4%多聚甲醛 (货号Y1112) 固定12-24小时. 抗原修复: 柠檬酸抗原修复液(干粉, pH 6.0) (Y1212), 高压锅均匀喷气计时2分钟. —抗: 1: 3000稀释, 4℃ 孵育过夜. 二抗: S-vision免疫组化多聚二抗(山羊抗兔),即用型 (货号Y1313), 室温孵育20分钟. |
|
|
IHC检测Fibronectin蛋白(货号 YB152104). 样品: 人肾, 4%多聚甲醛 (货号Y1112) 固定12-24小时. 抗原修复: 柠檬酸抗原修复液(干粉, pH 6.0) (Y1212), 高压锅均匀喷气计时2分钟. —抗: 1: 3000稀释, 4℃ 孵育过夜. 二抗: S-vision免疫组化多聚二抗(山羊抗兔),即用型 (货号Y1313), 室温孵育20分钟. |
|
|
IHC检测Fibronectin蛋白(货号 YB152104). 样品: 人肝癌, 4%多聚甲醛 (货号Y1112) 固定12-24小时. 抗原修复: 柠檬酸抗原修复液(干粉, pH 6.0) (Y1212), 高压锅均匀喷气计时2分钟. —抗: 1: 3000稀释, 4℃ 孵育过夜. 二抗: S-vision免疫组化多聚二抗(山羊抗兔),即用型 (货号Y1313), 室温孵育20分钟. |
|
|
IHC检测Fibronectin蛋白(货号 YB152104). 样品: 小鼠肺, 4%多聚甲醛 (货号Y1112) 固定12-24小时. 抗原修复: 柠檬酸抗原修复液(干粉, pH 6.0) (Y1212), 高压锅均匀喷气计时2分钟. —抗: 1: 3000稀释, 4℃ 孵育过夜. 二抗: S-vision免疫组化多聚二抗(山羊抗兔),即用型 (货号Y1313), 室温孵育20分钟. |
|
|
IHC检测Fibronectin蛋白(货号 YB152104). 样品: 小鼠肺, 4%多聚甲醛 (货号Y1112) 固定12-24小时. 抗原修复: 柠檬酸抗原修复液(干粉, pH 6.0) (Y1212), 高压锅均匀喷气计时2分钟. —抗: 1: 3000稀释, 4℃ 孵育过夜. 二抗: S-vision免疫组化多聚二抗(山羊抗兔),即用型 (货号Y1313), 室温孵育20分钟. |
|
|
IHC检测Fibronectin蛋白(货号 YB152104). 样品: 小鼠胃, 4%多聚甲醛 (货号Y1112) 固定12-24小时. 抗原修复: 柠檬酸抗原修复液(干粉, pH 6.0) (Y1212), 高压锅均匀喷气计时2分钟. —抗: 1: 3000稀释, 4℃ 孵育过夜. 二抗: S-vision免疫组化多聚二抗(山羊抗兔),即用型 (货号Y1313), 室温孵育20分钟. |
|
|
IHC检测Fibronectin蛋白(货号 YB152104). 样品: 大鼠肺, 4%多聚甲醛 (货号Y1112) 固定12-24小时. 抗原修复: 柠檬酸抗原修复液(干粉, pH 6.0) (Y1212), 高压锅均匀喷气计时2分钟. —抗: 1: 3000稀释, 4℃ 孵育过夜. 二抗: S-vision免疫组化多聚二抗(山羊抗兔),即用型 (货号Y1313), 室温孵育20分钟. |
|
|
IHC检测Fibronectin蛋白(货号 YB152104). 样品: 大鼠胃, 4%多聚甲醛 (货号Y1112) 固定12-24小时. 抗原修复: 柠檬酸抗原修复液(干粉, pH 6.0) (Y1212), 高压锅均匀喷气计时2分钟. —抗: 1: 3000稀释, 4℃ 孵育过夜. 二抗: S-vision免疫组化多聚二抗(山羊抗兔),即用型 (货号Y1313), 室温孵育20分钟. |
|
|
IF检测Fibronectin蛋白(货号 YB152104)(红色). 样品: 人结肠癌, 4%多聚甲醛 (货号Y1112) 固定12-24小时. 抗原修复: 柠檬酸抗原修复液(干粉, pH 6.0) (Y1212), 高压锅均匀喷气计时2分钟. 封闭: 3% BSA(货号YC305021)的PBS溶液, 室温孵育30分钟. —抗: 1: 3000稀释, 4℃ 孵育过夜. 二抗: Cy3标记山羊抗兔IgG (H+L) (货号YB21314), 1: 300稀释, 室温孵育1小时. |
|
|
IF检测Fibronectin蛋白(货号 YB152104)(红色). 样品: 人食管癌, 4%多聚甲醛 (货号Y1112) 固定12-24小时. 抗原修复: 柠檬酸抗原修复液(干粉, pH 6.0) (Y1212), 高压锅均匀喷气计时2分钟. 封闭: 3% BSA(货号YC305021)的PBS溶液, 室温孵育30分钟. —抗: 1: 3000稀释, 4℃ 孵育过夜. 二抗: Cy3标记山羊抗兔IgG (H+L) (货号YB21314), 1: 300稀释, 室温孵育1小时. |
|
|
IF检测Fibronectin蛋白(货号 YB152104)(红色). 样品: 人肺癌, 4%多聚甲醛 (货号Y1112) 固定12-24小时. 抗原修复: 柠檬酸抗原修复液(干粉, pH 6.0) (Y1212), 高压锅均匀喷气计时2分钟. 封闭: 3% BSA(货号YC305021)的PBS溶液, 室温孵育30分钟. —抗: 1: 3000稀释, 4℃ 孵育过夜. 二抗: Cy3标记山羊抗兔IgG (H+L) (货号YB21314), 1: 300稀释, 室温孵育1小时. |
|
|
IF检测Fibronectin蛋白(货号 YB152104)(红色). 样品: 人卵巢癌, 4%多聚甲醛 (货号Y1112) 固定12-24小时. 抗原修复: 柠檬酸抗原修复液(干粉, pH 6.0) (Y1212), 高压锅均匀喷气计时2分钟. 封闭: 3% BSA(货号YC305021)的PBS溶液, 室温孵育30分钟. —抗: 1: 3000稀释, 4℃ 孵育过夜. 二抗: Cy3标记山羊抗兔IgG (H+L) (货号YB21314), 1: 300稀释, 室温孵育1小时. |
|
|
IF检测Fibronectin蛋白(货号 YB152104)(红色). 样品: 小鼠肺, 4%多聚甲醛 (货号Y1112) 固定12-24小时. 抗原修复: 柠檬酸抗原修复液(干粉, pH 6.0) (Y1212), 高压锅均匀喷气计时2分钟. 封闭: 3% BSA(货号YC305021)的PBS溶液, 室温孵育30分钟. —抗: 1: 3000稀释, 4℃ 孵育过夜. 二抗: Cy3标记山羊抗兔IgG (H+L) (货号YB21314), 1: 300稀释, 室温孵育1小时. |
|
|
IF检测Fibronectin蛋白(货号 YB152104)(红色). 样品: 大鼠胃, 4%多聚甲醛 (货号Y1112) 固定12-24小时. 抗原修复: 柠檬酸抗原修复液(干粉, pH 6.0) (Y1212), 高压锅均匀喷气计时2分钟. 封闭: 3% BSA(货号YC305021)的PBS溶液, 室温孵育30分钟. —抗: 1: 3000稀释, 4℃ 孵育过夜. 二抗: Cy3标记山羊抗兔IgG (H+L) (货号YB21314), 1: 300稀释, 室温孵育1小时. |
储存
| 储存条件 | 在-20℃下储存一年, 避免反复冻融. |
| 储存缓冲液 | 含0.15% ProClin300防腐剂, 100 μg/mL牛血清白蛋白和50%甘油的磷酸盐缓冲液. |
注意:
1.本产品仅供研究使用.
2.建议用一抗稀释液(Y2036)稀释本产品.
| 货号 | 名称 | 规格 | 价格 | 操作 |
|---|
| 货号 | 名称 | 规格 | 价格 | 操作 |
|---|